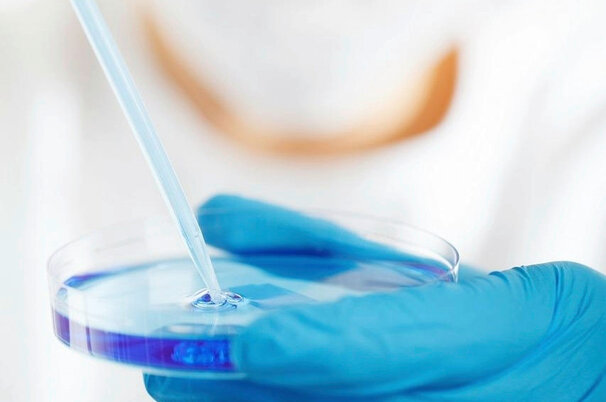

Artikel werden durchsucht.
Pflanzen
Pflanzenschutz
Invasive Arten bedrohen benachbarte Ökosysteme
Pflanzen
Wald
Warum Waldränder wichtiger werden
Pflanzen
Forschung
Regenwürmer bei nächtlicher Lichtverschmutzung weniger aktiv
Tiere
Übrige Tiere
Varroamilben schaden Honigbienen doppelt
Politik & Wirtschaft
Agrarwirtschaft
10’000 Bakterienstämme für den Schweizer Käse
Regionen
Westschweiz
Neuenburg investiert in nachhaltige Landwirtschaft
Pflanzen
Forschung
Studie: Genetische Vielfalt ungenügend überwacht
Tiere
Übrige Tiere
Was mit erlegten Wölfen passiert
Landtechnik
Neuheiten
Weltrekord mit Elektro Aebi geknackt
Pflanzen
Forschung
Evolution bei Pflanzen rückgängig gemacht
Das Wetter heute in
Lesershop
Umfrage

Wer macht die Büroarbeiten für den Hof?
- Hauptsächlich der Mann:54.45%
- Hauptsächlich die Frau:31.41%
- Beide zusammen:6.81%
- Ist nicht klar geregelt:7.33%
Teilnehmer insgesamt: 382
Bekanntschaften
Suchen Sie Kollegen und Kolleginnen für Freizeit und Hobbies? Oder eine Lebenspartnerin oder einen Lebenspartner?